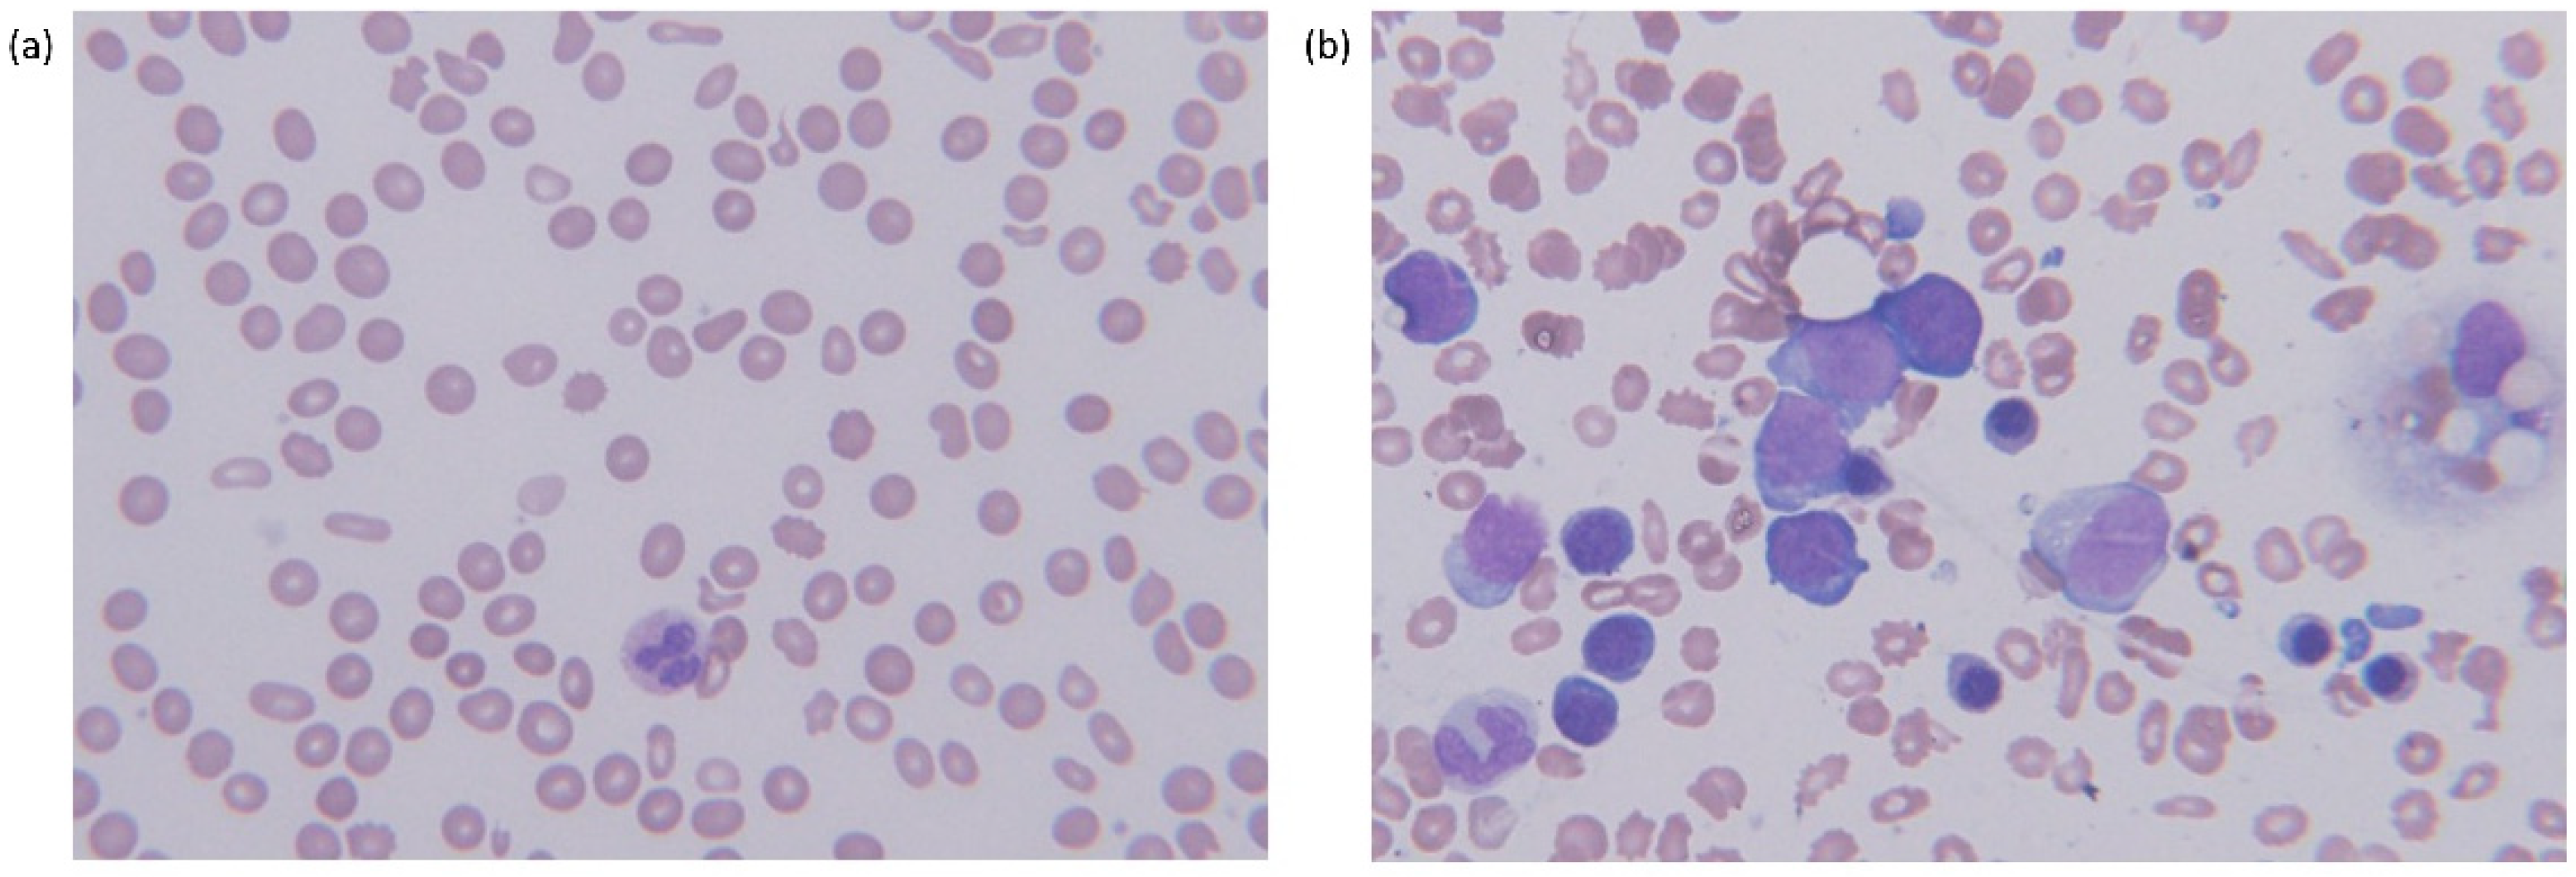
Diagnostics 11 01644 g001 Diagnostics 11 01644 g001

Abstract
Primary myelofibrosis (PMF) and paroxysmal nocturnal hemoglobinuria (PNH) are very rare diseases, respectively, and it is uncommon to have both diseases together. Mutational profiling using next-generation sequencing in PMF and PNH detected additional mutations associated with myeloid neoplasms, suggesting a step-wise clonal evolution. We present here a very rare case with PMF and PNH with JAK2 V617F, U2AF1 and SETBP1 mutations at the time of diagnosis. The combination of these two diseases and three genetic mutations is difficult to interpret at once. (i.e., the sequence of these two clonal diseases or the time points of acquiring these mutations). Our report suggests that when diagnosing or treating patients with PMF, it is necessary to keep in mind that PNH may be present at the same time or sometimes new. The genetic mutations simultaneously found in this patient require further research to elucidate the clinical significance and their genetic associations fully.
1. Introduction
Primary myelofibrosis (PMF) is one of the clonal myeloproliferative neoplasms (MPN) characterized by megakaryocytic and granulocytic proliferation in the bone marrow, resulting in bone marrow fibrosis and extramedullary hematopoiesis. Three driver mutations of Janus kinase 2 (JAK2), calreticulin (CALR) and myeloproliferative leukemia virus oncogene (MPL) are well implicated in MPN. In PMF patients, JAK2 V617F mutation is found in 55% to 65% of cases, while CALR and MPL mutations are observed in 25% to 30% of cases [1]. Through the wide use of next-generation sequencing (NGS) in clinical practices, in addition to the three driver mutations, other genetic mutations (i.e., ASXL1, EZH2, SRSF2, U2AF1Q157 and IDH1/2, etc.) have been reported in MPN [2,3,4,5,6].
Paroxysmal nocturnal hemoglobinuria (PNH) is characterized by chronic hemolysis and increased risk of thrombosis, which are caused by elevated complement activation in the phosphatidylinositol glycan class A (PIGA) deficient cells due to somatic PIGA mutation in hematopoietic stem cells [7]. Furthermore, the application of NGS in PNH patients demonstrated that the mutations of myeloid neoplasm-related genes (i.e., TET2, SUZ12, U2AF1, JAK2, ASXL1, DNMT3A, etc.) could be acquired in addition to the PIGA gene mutation [8,9,10].
There have been a few reports of the concomitant MPN and PNH [11,12,13,14,15,16,17], whereas a close association between PNH and aplastic anemia (AA)/myelodysplastic syndrome (MDS) has been well known [18].
Here, we report a case with the coexistence of PMF and PNH harboring JAK2, U2AF1 and SETBP1 gene mutations.
2. Case Presentation
An 87-year-old male was transferred to our hospital with a complaint of general weakness and dyspnea on exertion for two years. He has been diagnosed with severe anemia, thrombocytopenia, splenomegaly and newly developed multiple lymphadenopathies. He had a 2-year history of receiving periodic blood transfusions for iron deficiency anemia and other comorbidities included hypertension and cerebrovascular disease. Because the patient was transferred from another hospital, it was difficult to obtain detailed information about past diseases and treatments other than blood transfusion.
The CBC findings of peripheral blood were as follows: hemoglobin (Hgb) 6.0 g/dL, reticulocyte percentage 2.58%, calculated reticulocyte production index (RPI) 0.54; platelet count 128 × 109/L (Table 1). The white blood cell (WBC) count was 5.86 × 109/L with neutrophils 56%, band neutrophils 4%, metamyelocytes 2%, myelocytes 7%, blasts 1%, lymphocytes 13%, monocytes 12%, eosinophils 1% and basophils 4%. Peripheral blood smear showed RBC poikilocytosis, such as teat drop cells, elliptocytes and acanthocytes (Figure 1a).

Table 1.
Laboratory findings overtime.

Figure 1.
Morphologic features in peripheral blood and bone marrow aspirate of a primary myelofibrosis patient with PNH-clone, (a) peripheral blood showing pancytopenia with RBC poikilocytosis (Wright–Giemsa stain, ×400) and (b) bone marrow dilution with a few myeloblasts mixed with erythroid precursors (Wright–Giemsa stain, ×400).
The other laboratory findings were as follows; elevated lactate dehydrogenase (LDH) 640 IU/L, decreased haptoglobin (lower than detection limit), elevated erythropoietin 189 mIU/mL. However, other laboratory tests for evidence of hemolysis showed normal results; normal bilirubin, normal aspartate aminotransferase (AST) and alanine aminotransferase (ALT), normal plasma free hemoglobin, no hemoglobinuria, negative hemosiderin and negative direct or indirect Coombs’ tests (Table 1). A PNH test was also performed based on the thrombocytopenia associated with hemolytic anemia and negative Coomb’s test. PNH clones were identified in 3.8% of RBCs, 48.6% of neutrophils and 77.2% of monocytes using flow cytometric analysis using CD59 for RBCs and FLAER & CD24 for WBCs. These results suggest extravascular hemolysis.
Computed tomography (CT) and Positron Emission Tomography (PET)/CT scan showed splenomegaly, two masses in the inferior portion of the spleen, multiple lymphadenopathies and hypermetabolism in the bone marrow. Splenic or portal vein thromboses were not found. Splenic fine needle biopsy revealed extramedullary hematopoiesis. A bone marrow (BM) aspirate was diluted but showed clusters of myeloid precursors (Figure 1b). BM core biopsy revealed overt myelofibrosis with megakaryocytic hyperplasia and atypia (Figure 2). Conventional cytogenetic analysis showed normal karyotype, 46,XY. Molecular analysis using targeted NGS (Oncomine Myeloid Research Assay, Ion Torrent, Thermo Fisher Scientific) revealed JAK2 V617F with 50.9% variant allele frequency (VAF). In addition, U2AF1 and SETBP1 missense mutations were identified: U2AF1, NM_001025203.1:c.470A > C, (p.Gln157Pro) with 44.7% of VAF; SETBP1, NM_015559.3:c.2608G > A, (p.Gly870Ser) with 5.2% of VAF.

Figure 2.
Diffuse myelofibrosis in bone marrow core biopsy, (a) hematoxylin and eosin stain (×100), (b) reticulin fibrosis by retuculin stain (×100) and (c) collagen fibrosis by Masson’s trichrome stain (×100).
Based on the World Health Organization (WHO) 2016 criteria, he was diagnosed as overt primary myelofibrosis with PNH-clones. The risk stratification of PMF based on Dynamic International Prognostic Scoring System (DIPSS) Plus [19] was DPISS Plus score 5, a high-risk group; age > 65 years, constitutional symptoms such as inactivity and fatigue, hemoglobin < 10 g/dL, circulating blasts 1% and transfusion dependency. Evaluating the symptom burden using the Myeloproliferative Neoplasm Symptom Assessment Form Total Symptom Score (MPN-SAF TSS) [20], the score was 9 showing symptoms of early satiety and problems with concentration. He started treatment with a ruxolitinib dose of 15 mg twice daily with a baseline platelet count of 100 × 109/L or more. Eculizumab treatment for PNH clones did not meet the reimbursement standards of the National Health Insurance Service in our country because there was no evidence for thrombosis, hemolysis, or hemoglobinuria. In the future, eculizumab treatment should be considered depending on the increase in PNH clones and whether hemolysis or thrombosis proceed.
At the follow-up visit two weeks after ruxolitinib treatment, thrombocytopenia progressed with general weakness (Table 1). Therefore, the patient was treated at a reduced dose of ruxolitinib 10 mg twice a day. At the 4th week of ruxolitinib treatment, anemia and thrombocytopenia worsened (Table 1) and MPN-SAF TSS was 20 showing symptoms of fatigue, early satiety, inactivity and problems with concentration. He has temporarily discontinued the treatment with ruxolitinib. One week later, the patient was hospitalized with fever, cough and sputum and was diagnosed with pneumonia. It is now four weeks after withholding of ruxolitinib treatment and the cytopenias have not yet recovered (Table 1).
3. Discussion
Our patient showed coexistence of PMF and PNH clones accompanied by JAK2, U2AF1 and SETBP1 gene mutations. In PMF, high molecular risk mutations include ASXL1, EZH2, SRSF2, U2AF1Q157 and IDH1/2, according to the mutation-enhanced International Prognostic Scoring System (MIPSS-70) [4,5]. The U2AF1 mutations were observed in 9.3–16% of PMF patients [3,21] and it is known to be associated with poor survival [22,23]. On the other hand, the SETBP1 mutation is rare in PMF patients (0.3–2.4%) [3,6,24,25], while SETBP1 was identified in atypical chronic myelogenous leukemia (CML) with a frequency of 32% [24]. One report states that increased SETBP1 gene expression is associated with a progression from PMF to acute myeloid leukemia (AML) [26]. However, it is still insufficient to conclude the clinical significance of SETBP1 mutation in PMF patients.
Furthermore, myeloid neoplasm-related gene (TET2, SUZ12, U2AF1 and JAK2) mutations found in MPN were identified in 83% of PNH patients by NGS [8]. The analysis on hierarchical clonal architecture suggested that such additional mutations arose as a subclone in PIGA-mutated cells or prior to PIGA mutation [8]. The other study also demonstrated that PNH patients showed multiple somatic mutations along with PIGA gene mutation and especially SETBP1 mutation was also found [10]. Taken together, mutations of JAK2, U2AF1 and SETBP1 found in our patient were reported associated with either PMF or PNH clones. In PNH, acquiring additional MPN-associated gene mutations might promote clonal expansion of the PIGA mutant clone, consequently inducing clinical manifestation of both MPN and PNH [27].
Interestingly, a few cases of coexistence of PMF and PNH have been reported (Table 2) [11,12,14,16]. One recent study reported that PNH clones were found in 2% of MPN patients [15]. The sequence of development of these two clonal diseases or the time points of acquiring these associated mutations has been reported to be variable case by case. According to the previous reports, some patients were initially diagnosed with MPN and PNH together, harboring concomitant MPN associated genes and PIGA gene mutations [14,16,17,27]. Another report showed that patients were initially diagnosed with MPN, following eventual evolution of PNH [11,12,13], while other patient was diagnosed as PNH at first and then developed MPN later [12]. Taken together, MPN and PNH association may be attributed to the PNH clone arising either from the MPN-mutated populations or in parallel with the MPN mutated populations and vice versa.

Table 2.
Cases of PMF patients with concurrent paroxysmal nocturnal hemoglobinuria (PNH).
Thrombosis is a common and fatal complication in both MPN and PNH [7,28]. A meta-analysis pooled from 29 cohort studies reported that thrombosis occurred in 20% of patients with MPN [29]. The thrombophilic condition in MPN is caused by quantitative and qualitative changes of blood cells due to the increase in clonal cells of hematopoietic stem cells [28]. Age (>60 or 65 years of age) and a history of thrombosis are independent predictors of thrombosis in MPN patients [28]. JAK2 V617F was found in 40.9% and 31.5% of patients with Budd Chiari syndrome or portal vein thrombosis, suggesting that MPN is implicated in thrombotic conditions [30]. On the other hand, among MPN patients, thrombotic events were reported at a lower rate in PMF patients than in polycythemia vera or essential thrombocythemia [28].
In PNH, the thrombotic tendency is caused by several factors, while the interplay between complement and coagulation systems plays a significant role [7]. PNH clone size has been proven to be associated with the risk of thrombosis [31]. A PNH case developed from a hemolytic episode to a thromboembolic episode after suffering from PNH disease for 15 years, indicating that the nature of the disease might change with age [32]. Although the main symptom of PNH is caused by intravascular hemolysis, it should note that the risk of thrombosis may increase in advanced age. Our patient was of advanced age at diagnosis, but the follow-up period was short. Thrombotic episodes should be carefully monitored to see if treatment with the anti-complement agent, eculizumab, is required in the future.
In MPN patients with a high risk of thrombosis, useful prognostic and predictable biomarkers are needed. Recently, there have been reports suggesting the potential for diagnosing MPN and predicting thrombosis as a biomarker using liquid biopsy and liquid biopsy-based biomarkers in MPNs [33]. In MPN patients experiencing thrombosis, cell-free DNA, circulating endothelial cells, microparticles (MPs), tissue factors with MPs and procoagulant activity of MPs in peripheral blood were increased and platelet-derived MPs was decreased [33]. When there are complex prognostic factors, such as in this case, biomarkers derived from liquid biopsy have the potential to help predict the prognosis.
Our patient showed coexistence of PMF and PNH clone accompanied by JAK2, U2AF1 and SETBP1 gene mutations at the first visit to our hospital. However, this patient’s lack of previous clinical history due to a referral from another hospital prevents us from investigating the sequence of these two clonal diseases or the time points of acquiring these mutations. The clinical significance of the coexistence of PMF and PNH clone has not been fully elucidated yet (i.e., how PNH clones could influence MPN phenotype and complication). The complex pathogenesis of these two diseases leaves us with further investigations for clinical significance in a large cohort.
Author Contributions
Designed this study, S.P. and J.H.; participated in diagnosis and management of this patient and provided expertise, M.-K.S., M.-S.C. and D.-Y.K.; wrote this manuscript, S.P.; supervised this study, J.H. All authors have read and agreed to the published version of the manuscript.
Funding
This research received no external funding.
Institutional Review Board Statement
Ethical review and approval were waived for this study under the Korean Bioethics and Safety Act, because the research does not cause any harm to individuals or society.
Informed Consent Statement
Informed consent was waived, since no data that can potentially and clearly identify the patient were found in the case description.
Conflicts of Interest
The authors declare no conflict of interest.
References
- Tefferi, A.; Guglielmelli, P.; Larson, D.R.; Finke, C.; Wassie, E.A.; Pieri, L.; Gangat, N.; Fjerza, R.; Belachew, A.A.; Lasho, T.L.; et al. Long-term survival and blast transformation in molecularly annotated essential thrombocythemia, polycythemia vera, and myelofibrosis. Blood 2014, 124, 2507–2513. [Google Scholar] [CrossRef] [PubMed]
- Vannucchi, A.M.; Lasho, T.L.; Guglielmelli, P.; Biamonte, F.; Pardanani, A.; Pereira, A.; Finke, C.; Score, J.; Gangat, N.; Mannarelli, C.; et al. Mutations and prognosis in primary myelofibrosis. Leukemia 2013, 27, 1861–1869. [Google Scholar] [CrossRef] [PubMed]
- Song, J.; Hussaini, M.; Zhang, H.; Shao, H.; Qin, D.; Zhang, X.; Ma, Z.; Hussnain Naqvi, S.M.; Zhang, L.; Moscinski, L.C. Comparison of the Mutational Profiles of Primary Myelofibrosis, Polycythemia Vera, and Essential Thrombocytosis. Am. J. Clin. Pathol. 2017, 147, 444–452. [Google Scholar] [CrossRef] [PubMed]
- Tefferi, A.; Guglielmelli, P.; Lasho, T.L.; Gangat, N.; Ketterling, R.P.; Pardanani, A.; Vannucchi, A.M. MIPSS70+ Version 2.0: Mutation and Karyotype-Enhanced International Prognostic Scoring System for Primary Myelofibrosis. J. Clin. Oncol. 2018, 36, 1769–1770. [Google Scholar] [CrossRef]
- Guglielmelli, P.; Lasho, T.L.; Rotunno, G.; Mudireddy, M.; Mannarelli, C.; Nicolosi, M.; Pacilli, A.; Pardanani, A.; Rumi, E.; Rosti, V.; et al. MIPSS70: Mutation-Enhanced International Prognostic Score System for Transplantation-Age Patients with Primary Myelofibrosis. J. Clin. Oncol. 2018, 36, 310–318. [Google Scholar] [CrossRef] [PubMed]
- Grinfeld, J.; Nangalia, J.; Baxter, E.J.; Wedge, D.C.; Angelopoulos, N.; Cantrill, R.; Godfrey, A.L.; Papaemmanuil, E.; Gundem, G.; MacLean, C.; et al. Classification and Personalized Prognosis in Myeloproliferative Neoplasms. N. Engl. J. Med. 2018, 379, 1416–1430. [Google Scholar] [CrossRef] [PubMed]
- Hill, A.; Kelly, R.J.; Hillmen, P. Thrombosis in paroxysmal nocturnal hemoglobinuria. Blood 2013, 121, 4985–4996. [Google Scholar] [CrossRef]
- Shen, W.; Clemente, M.J.; Hosono, N.; Yoshida, K.; Przychodzen, B.; Yoshizato, T.; Shiraishi, Y.; Miyano, S.; Ogawa, S.; Maciejewski, J.P.; et al. Deep sequencing reveals stepwise mutation acquisition in paroxysmal nocturnal hemoglobinuria. J. Clin. Investig. 2014, 124, 4529–4538. [Google Scholar] [CrossRef] [PubMed]
- Li, J.; Lin, Y.; Chen, L.; Qin, L.; Tan, H.; Zou, J.; Zhang, D.; Nie, Y.; Wang, G.; Zhang, H.; et al. Identification of acquired PIGA mutations and additional variants by next-generation sequencing in paroxysmal nocturnal hemoglobinuria. Int. J. Lab. Hematol. 2020, 42, 473–481. [Google Scholar] [CrossRef]
- Chen, F.; Hu, S.; Ruan, J.; Chen, M.; Han, B. Mutational landscape and its clinical significance in paroxysmal nocturnal hemoglobinuria. Blood Cancer J. 2021, 11, 58. [Google Scholar] [CrossRef] [PubMed]
- Shaheen, S.P., 2nd; Talwalkar, S.S.; Simons, R.; Yam, L. Acute lymphoblastic leukemic transformation in a patient with chronic idiopathic myelofibrosis and paroxysmal nocturnal hemoglobinuria: A case report and review of the literature. Arch. Pathol. Lab. Med. 2005, 129, 96–99. [Google Scholar] [CrossRef]
- Sugimori, C.; Padron, E.; Caceres, G.; Shain, K.; Sokol, L.; Zhang, L.; Tiu, R.; O’Keefe, C.L.; Afable, M.; Clemente, M.; et al. Paroxysmal nocturnal hemoglobinuria and concurrent JAK2(V617F) mutation. Blood Cancer J. 2012, 2, e63. [Google Scholar] [CrossRef] [PubMed]
- Fraiman, Y.S.; Cuka, N.; Batista, D.; Vuica-Ross, M.; Moliterno, A.R. Development of paroxysmal nocturnal hemoglobinuria in CALR-positive myeloproliferative neoplasm. J. Blood Med. 2016, 7, 107–110. [Google Scholar]
- Gaidano, V.; Geuna, M.; Cignetti, A.; Carnuccio, F.; Bernabei, P.; Santoro, N.; Saglio, G.; Sivera, P. Myeloproliferative neoplasms, thrombosis and paroxysmal nocturnal hemoglobinuria: Is this triad more frequent than we thought? Hematol. Med. Oncol. 2017, 2, 4–5. [Google Scholar] [CrossRef]
- Gutwein, O.; Englander, Y.; Herzog-Tzarfati, K.; Filipovich-Rimon, T.; Apel, A.; Marcus, R.; Rahimi-Levene, N.; Koren-Michowitz, M. Prevalence of Paroxysmal Nocturnal Hemoglobinuria Clones in Myeloproliferative Neoplasm Patients: A Cross-Sectional Study. Clin. Lymphoma Myeloma Leuk. 2019, 19, 812–814. [Google Scholar] [CrossRef] [PubMed]
- Kirito, K. Expansion of paroxysmal nocturnal hemoglobinuria clones in MPLW515L mutation harboring primary myelofibrosis. Ann. Hematol. 2020, 99, 2707–2709. [Google Scholar] [CrossRef]
- Chatzidavid, S.; Giannakopoulou, N.; Diamantopoulos, P.T.; Gavriilaki, E.; Katsiampoura, P.; Lakiotaki, E.; Sakellariou, S.; Viniou, N.A.; Dryllis, G. JAK2V617F positive polycythemia vera with paroxysmal nocturnal hemoglobinuria and visceral thromboses: A case report and review of the literature. Thromb. J. 2021, 19, 16. [Google Scholar] [CrossRef]
- Fattizzo, B.; Ireland, R.; Dunlop, A.; Yallop, D.; Kassam, S.; Large, J.; Gandhi, S.; Muus, P.; Manogaran, C.; Sanchez, K.; et al. Clinical and prognostic significance of small paroxysmal nocturnal hemoglobinuria clones in myelodysplastic syndrome and aplastic anemia. Leukemia 2021. [Google Scholar] [CrossRef]
- Gangat, N.; Caramazza, D.; Vaidya, R.; George, G.; Begna, K.; Schwager, S.; Van Dyke, D.; Hanson, C.; Wu, W.; Pardanani, A.; et al. DIPSS plus: A refined Dynamic International Prognostic Scoring System for primary myelofibrosis that incorporates prognostic information from karyotype, platelet count, and transfusion status. J. Clin. Oncol. 2011, 29, 392–397. [Google Scholar] [CrossRef]
- Emanuel, R.M.; Dueck, A.C.; Geyer, H.L.; Kiladjian, J.J.; Slot, S.; Zweegman, S.; te Boekhorst, P.A.; Commandeur, S.; Schouten, H.C.; Sackmann, F.; et al. Myeloproliferative neoplasm (MPN) symptom assessment form total symptom score: Prospective international assessment of an abbreviated symptom burden scoring system among patients with MPNs. J. Clin. Oncol. 2012, 30, 4098–4103. [Google Scholar] [CrossRef]
- Tefferi, A.; Lasho, T.L.; Finke, C.M.; Elala, Y.; Hanson, C.A.; Ketterling, R.P.; Gangat, N.; Pardanani, A. Targeted deep sequencing in primary myelofibrosis. Blood Adv. 2016, 1, 105–111. [Google Scholar] [CrossRef]
- Tefferi, A.; Finke, C.M.; Lasho, T.L.; Hanson, C.A.; Ketterling, R.P.; Gangat, N.; Pardanani, A. U2AF1 mutation types in primary myelofibrosis: Phenotypic and prognostic distinctions. Leukemia 2018, 32, 2274–2278. [Google Scholar] [CrossRef]
- Engle, E.K.; Fisher, D.A.; Miller, C.A.; McLellan, M.D.; Fulton, R.S.; Moore, D.M.; Wilson, R.K.; Ley, T.J.; Oh, S.T. Clonal evolution revealed by whole genome sequencing in a case of primary myelofibrosis transformed to secondary acute myeloid leukemia. Leukemia 2015, 29, 869–876. [Google Scholar] [CrossRef]
- Meggendorfer, M.; Bacher, U.; Alpermann, T.; Haferlach, C.; Kern, W.; Gambacorti-Passerini, C.; Haferlach, T.; Schnittger, S. SETBP1 mutations occur in 9% of MDS/MPN and in 4% of MPN cases and are strongly associated with atypical CML, monosomy 7, isochromosome i(17)(q10), ASXL1 and CBL mutations. Leukemia 2013, 27, 1852–1860. [Google Scholar] [CrossRef]
- Eder-Azanza, L.; Hurtado, C.; Navarro-Herrera, D.; Calavia, D.; Novo, F.J.; Vizmanos, J.L. Analysis of genes encoding epigenetic regulators in myeloproliferative neoplasms: Coexistence of a novel SETBP1 mutation in a patient with a p.V617F JAK2 positive myelofibrosis. Mol. Clin. Oncol. 2019, 10, 639–643. [Google Scholar] [CrossRef] [PubMed]
- Albano, F.; Anelli, L.; Zagaria, A.; Coccaro, N.; Casieri, P.; Minervini, A.; Specchia, G. SETBP1 and miR_4319 dysregulation in primary myelofibrosis progression to acute myeloid leukemia. J. Hematol. Oncol. 2012, 5, 48. [Google Scholar] [CrossRef] [PubMed]
- Okamoto, H.; Uoshima, N.; Kamitsuji, Y.; Kawata, E.; Komori, Y.; Sasaki, N.; Tsutsumi, Y.; Tsukamoto, T.; Mizutani, S.; Nannya, Y.; et al. Paroxysmal nocturnal hemoglobinuria complicated with essential thrombocythemia harboring concomitant PIGA, CALR, and ASXL1 mutations. Ann. Hematol. 2021, 100, 2113–2115. [Google Scholar] [CrossRef] [PubMed]
- Barbui, T.; Finazzi, G.; Falanga, A. Myeloproliferative neoplasms and thrombosis. Blood 2013, 122, 2176–2184. [Google Scholar] [CrossRef]
- Rungjirajittranon, T.; Owattanapanich, W.; Ungprasert, P.; Siritanaratkul, N.; Ruchutrakool, T. A systematic review and meta-analysis of the prevalence of thrombosis and bleeding at diagnosis of Philadelphia-negative myeloproliferative neoplasms. BMC Cancer 2019, 19, 184. [Google Scholar] [CrossRef]
- Smalberg, J.H.; Arends, L.R.; Valla, D.C.; Kiladjian, J.J.; Janssen, H.L.; Leebeek, F.W. Myeloproliferative neoplasms in Budd-Chiari syndrome and portal vein thrombosis: A meta-analysis. Blood 2012, 120, 4921–4928. [Google Scholar] [CrossRef]
- Hall, C.; Richards, S.; Hillmen, P. Primary prophylaxis with warfarin prevents thrombosis in paroxysmal nocturnal hemoglobinuria (PNH). Blood 2003, 102, 3587–3591. [Google Scholar] [CrossRef] [PubMed]
- Gaman, M.A.; Ursuleac, I.; Coriu, D. Paroxysmal nocturnal hemoglobinuria: Pandora’s box? J. Mind Med. Sci. 2020, 7, 19. [Google Scholar] [CrossRef]
- Gaman, M.A.; Cozma, M.A.; Dobrica, E.C.; Cretoiu, S.M.; Gaman, A.M.; Diaconu, C.C. Liquid Biopsy and Potential Liquid Biopsy-Based Biomarkers in Philadelphia-Negative Classical Myeloproliferative Neoplasms: A Systematic Review. Life 2021, 11, 677. [Google Scholar] [CrossRef] [PubMed]
Publisher’s Note: MDPI stays neutral with regard to jurisdictional claims in published maps and institutional affiliations. |
© 2021 by the authors. Licensee MDPI, Basel, Switzerland. This article is an open access article distributed under the terms and conditions of the Creative Commons Attribution (CC BY) license (https://creativecommons.org/licenses/by/4.0/).